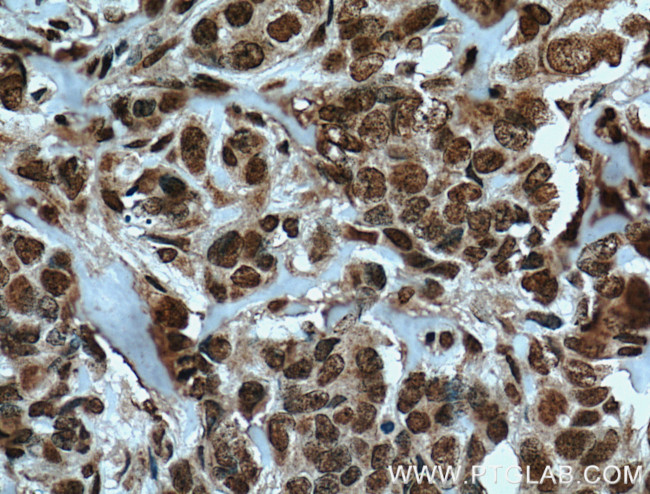
TRIM24 Antibody in Immunohistochemistry (Paraffin) (IHC (P))

Search
Proteintech
TRIM24 Monoclonal Antibody (1D6D9)
{{$productOrderCtrl.translations['antibody.pdp.commerceCard.promotion.promotions']}}
{{$productOrderCtrl.translations['antibody.pdp.commerceCard.promotion.viewpromo']}}
{{$productOrderCtrl.translations['antibody.pdp.commerceCard.promotion.promocode']}}: {{promo.promoCode}} {{promo.promoTitle}} {{promo.promoDescription}}. {{$productOrderCtrl.translations['antibody.pdp.commerceCard.promotion.learnmore']}}
产品信息
66324-1-IG
种属反应
宿主/亚型
分类
类型
克隆号
抗原
偶联物
形式
浓度
规格
纯化类型
保存液
内含物
保存条件
运输条件
产品详细信息
Immunogen sequence: SKPAGADST HKVPVVMLEP IRIKQENSGP PENYDFPVVI VKQESDEESR PQNANYPRSI LTSLLLNSSQ SSTSEETVLR SDAPDSTGDQ PGLHQDNSSN GKSEWLDPSQ KSPLHVGETR KEDDPNEDWC AVCQNGGELL CCEKCPKVFH LSCHVPTLTN FPSGEWICTF CRDLSKPEVE YDCDAPSHNS EKKKTEGLVK LTPIDKRKCE RLLLFLYCHE MSLAFQDPVP LTVPDYYKII KNPMDLSTIK KRLQEDYSMY SKPEDFVADF RLIFQNCAEF NEPDSEVANA GIKLENYFEE LLKNLYPEKR FPKPEFRNES EDNKFSDDSD DDFVQPRKKR LKSIEERQLL K (701-1050 aa encoded by BC028689)
靶标信息
The protein encoded by this gene mediates transcriptional control by interaction with the activation function 2 (AF2) region of several nuclear receptors, including the estrogen, retinoic acid, and vitamin D3 receptors. The protein localizes to nuclear bodies and is thought to associate with chromatin and heterochromatin-associated factors. The protein is a member of the tripartite motif (TRIM) family. The TRIM motif includes three zinc-binding domains - a RING, a B-box type 1 and a B-box type 2 - and a coiled-coil region. Two alternatively spliced transcript variants encoding different isoforms have been described for this gene.
仅用于科研。不用于诊断过程。未经明确授权不得转售。
篇参考文献 (0)
生物信息学
蛋白别名: Ab2-427; E3 ubiquitin-protein ligase TRIM24; RING finger protein 82; RING-type E3 ubiquitin transferase TIF1-alpha; TIF1-alpha; Transcription intermediary factor 1-alpha; transcriptional intermediary factor 1; transcriptional intermediary factor 1, alpha; Tripartite motif-containing protein 24; unnamed protein product
基因别名: A130082H20Rik; AI447469; D430004I05Rik; hTIF1; PTC6; RNF82; TF1A; TIF1; TIF1-alpha; TIF1A; TIF1ALPHA; TRIM24
UniProt ID: (Human) O15164, (Mouse) Q64127
Entrez Gene ID: (Human) 8805, (Rat) 500084, (Mouse) 21848